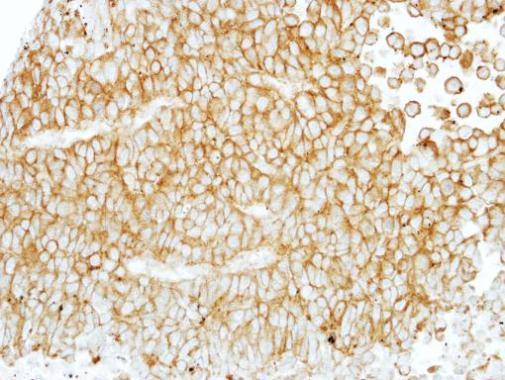

0 item(s)
View cart
You have no items in your shopping cart.
| Product Name | F4/80 antibody , C-term |
|---|---|
| Antibody Type | Primary Antibodies |
| Product description |
Rabbit Polyclonal antibody to F4/80 (egf-like module containing, mucin-like, hormone receptor-like 1)This gene encodes a protein that has a domain resembling seven transmembrane G protein-coupled hormone receptors (7TM receptors) at its C-terminus. The N-terminus of the encoded protein has six EGF-like modules, separated from the transmembrane segments by a serine/threonine-rich domain, a feature reminiscent of mucin-like, single-span, integral membrane glycoproteins with adhesive properties. [provided by RefSeq]
|
| Immunogen | Recombinant protein encompassing a sequence within the C-terminus region of human EMR1. The exact sequence is proprietary. |
| Clonality | Polyclonal |
|---|---|
| Isotype | IgG |
| Host Species | Rabbit |
| Tested Applications | ICC/IF IHC WB |
|
*Optimal dilutions/concentrations should be determined by the researcher.:
|
|
| Species Reactivity | Human Mouse Rat |
| Predicted Reactivity | DogDog (83%) |
| Concentration | 1 mg/ml (Please refer to the vial label for the specific concentration) |
| Purification | Affinity purified |
| Molecular Weight(MW) | 98 kDa (note) (4) |
|---|---|
| Gene Synonyms |
TM7LN3 antibody
EMR1 antibody EMR1 hormone receptor antibody EGF-like module receptor 1 antibody EGF-like module-containing mucin-like hormone receptor-like 1 antibody egf-like module containing mucin-like hormone receptor-like sequence 1 antibody |
| Cellular Localization | Cell membrane; Multi-pass membrane protein |

Positive Control Jurkat , Raji , K562 , C8D30 , NIH-3T3 , Raw264.7 , C2C12 , rat liver
Application Notes *Optimal dilutions/concentrations should be determined by the researcher.:
| Form | Liquid |
|---|---|
| Storage Instructions | Keep as concentrated solution. Aliquot and store at -20ºC or below. Avoid multiple freeze-thaw cycles. |
| Storage Buffer | 0.1M Tris, 0.1M Glycine, 10% Glycerol (pH7). 0.01% Thimerosal was added as a preservative. |
Note: The product is for research use only,not for use in diagnostic or therapeutic procedures.
When can I expect my order to ship?
Most orders are filled and shipped within 2-3 business days from the time they are received.
Our standard shipping usually take 2-5 days.
We also provide express shippping for time-sensitive deliveries.
Email contact@biofargo.com if you have any requirements.
| Features |
| Availability: |
| Price |
| Options |
| Actions |